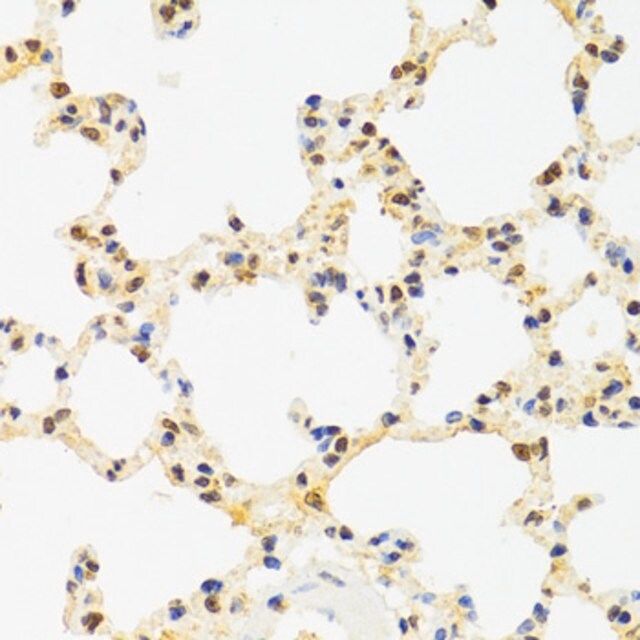
AntiSUZ12 antibody produced in rabbit

SUZ12(suppressor of zeste 12 homolog)は、ヒトではSUZ12遺伝子によってコードされているタンパク質である。
機能
SUZ12遺伝子は子宮内膜間質肉腫で頻発することが報告されている染色体転座の切断点に同定されている遺伝子であり、ジンクフィンガータンパク質をコードしている。こうした切断点での組換えによって、JAZF1との融合遺伝子が形成される。SUZ12はC末端にジンクフィンガードメインを有する。
SUZ12はPRC2複合体の一部として、HOTAIRノンコーディングRNAとともにクロマチンのサイレンシングに関与している可能性がある。ジンクフィンガードメインはRNA分子との結合に利用される。
出典
関連文献
外部リンク
- FactorBook SUZ12